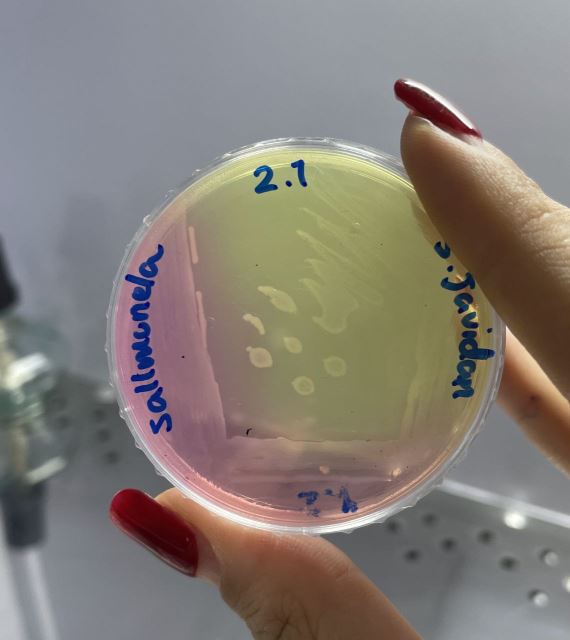
دوره جامع میکروب شناسی

درباره مرکز تخصصی ویراژن
-مرکز تخصصی آموزشی زیست فناوری ویراژن
-اولین آموزشگاه رسمی زیست فناوری در بوشهر و جنوب کشور
-برگزار کننده دوره های تخصصی علوم آزمایشگاهی ، تشخیص طبی و مولکولی طبق سرفصل های استاندارد جهانی
- همراه با اعطا مدرک مهارتی بین المللی از سازمان فنی و حرفه ای کشور
تماس: 09170400380
واتساپ و تلگرام: 09170400380
https://www.Instagram.com/vira_gene
ادرس: بوشهر- خیابان سنگی شرقی- نبش بلوار جمهوری- پلاک 138
آموزشگاه ویراژن:
-دارای 4 مجوز تخصصی آموزشی زیست فناوری
- دارای پروانه تاسیس از سازمان فنی و حرفه ای کشور
- برگزار کننده دوره های تخصصی مرتبط با علوم آزمایشگاهی و بخش مولکولی ویژه دانشجویان و فارغ التحصیلان رشته های تخصصی مرتبط با علوم آزمایشگاهی
- همراه با اعطا مدرک مهارتی بین المللی از سازمان فنی و حرفه ای کشور
آموزش و مهارت آموزی زیر نظر اساتید مجرب
طبق سرفصل های استاندارد جهانی فنی و حرفه ای کشور
اعتبار مدارک مهارتی بین المللی سازمان فنی و حرفه ای :
- دارای QR Code جهانی
- دارای کد استاندارد جهانی مهارت
- دارای شناسه قابل استعلام
- معتبر در تمامی کشورهای عضو سازمان جهانی کار به عنوان رزومه مهارتی
دوره های در حال برگزاری در مرکز تخصصی ویراژن
_فن ورز خونگیری و پذیرش ازمایشگاه تشخیص طبی
- دورهجامعمیکروب شناسی
- دوره هماتولوژی
- دورهکار با دستگاه الایزا (هورمون شناسی)
- دوره Real time PCR
- دوره کشت سلولی
- دورهطراحیپرایمر
- دوره کنترل کیفی آزمایشگاه تشخیص طبی
- دوره آنالیز ادرار
- دورهنمونهبرداری از مواد غذایی
- دوره کمکهای اولیه
-دوره تکنسین داروخانه
-دوره مقاله نویسی
و…
مجوزهای مرکز ویراژن
1)پروانه تاسیس از مرکز فنی و حرفه ای کشور
2) ثبت موسسه در اداره ثبت موسسات و شرکت ها
3) اداره صنعت ، معدن ، تجارت ( برایاولینبار و تنها مرکز در استان بوشهر، اموزش درحیطه زیست فناوری )
4- سازمان غذا و دارو ( برای اولین بار در استان بوشهر، اموزش نیروی نمونه بردار جهت ازمایشگاه های معاونت غذا و دارو همراه با اعطای گواهی دارای امتیاز باز آموزی )
ارتباط با ما
محصولات